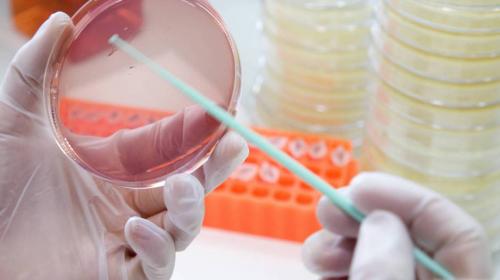

"Si estás tomando antibióticos, no puedes beber alcohol", suelen decir padres, amigos y familiares. Pero, es probable que siempre te preguntes por qué no hacerlo.
Según la ciencia, existen algunos antibióticos que reaccionan muy mal con el alcohol. Aunque esto no implique que sea mortal, es muy probable que con esa mezcla tengas un rato poco agradable.
Por eso, a continuación encontrarás cuatro de los antibióticos severamente contraindicados cuando se mezclan con alcohol.
- LEE TAMBIÉN
Metronidazol: este antibiótico de amplio espectro se puede usar tanto para infecciones de las vías respiratorias como dentales o ginecológicas. Mezclado con alcohol puede provocar cólicos, náusea, dolor de cabeza y diarrea.
Tinidazol: los médicos recomiendan no tomar alcohol incluso tres días más tarde de haber terminado el tratamiento. Entre los síntomas de mezclarlo se encuentran malestar estomacal, vómitos, cólicos, dolor de cabeza, transpiración excesiva y rubor (enrojecimiento de la cara).
Linezolid: mezclado con alcohol puede producir somnolencia excesiva, mareos y dificultad para concentrarte. Esto puede ser muy peligroso si manejas algún tipo de maquinaria o conduces a casa.
Doxiciclina: este antibiótico junto con el alcohol causa somnolencia, dolor de cabeza, desorientación, alucinaciones, calambres y alteraciones del ritmo cardíaco.
El alcohol disminuye la efectividad de los antibióticos
El problema con el alcohol es que hace que tu organismo no funcione al 100%. Por ello, si lo ingieres mientras te encuentras en un tratamiento, solamente te hará alargar el tiempo de medicación.
Por supuesto, todo esto se agrava si eres mayor o tienes tu salud deteriorada de alguna manera.
- TAMBIÉN TE INTERESA
¿Existe algún antibiótico que se pueda mezclar con alcohol?
Exactamente ninguno que un médico en su sano juicio pueda recomendar. Lo mejor es que, si te estás tratando una infección con antibióticos, no ingieras nada de alcohol hasta pasados unos días del tratamiento.
*Con información de Gizmodo